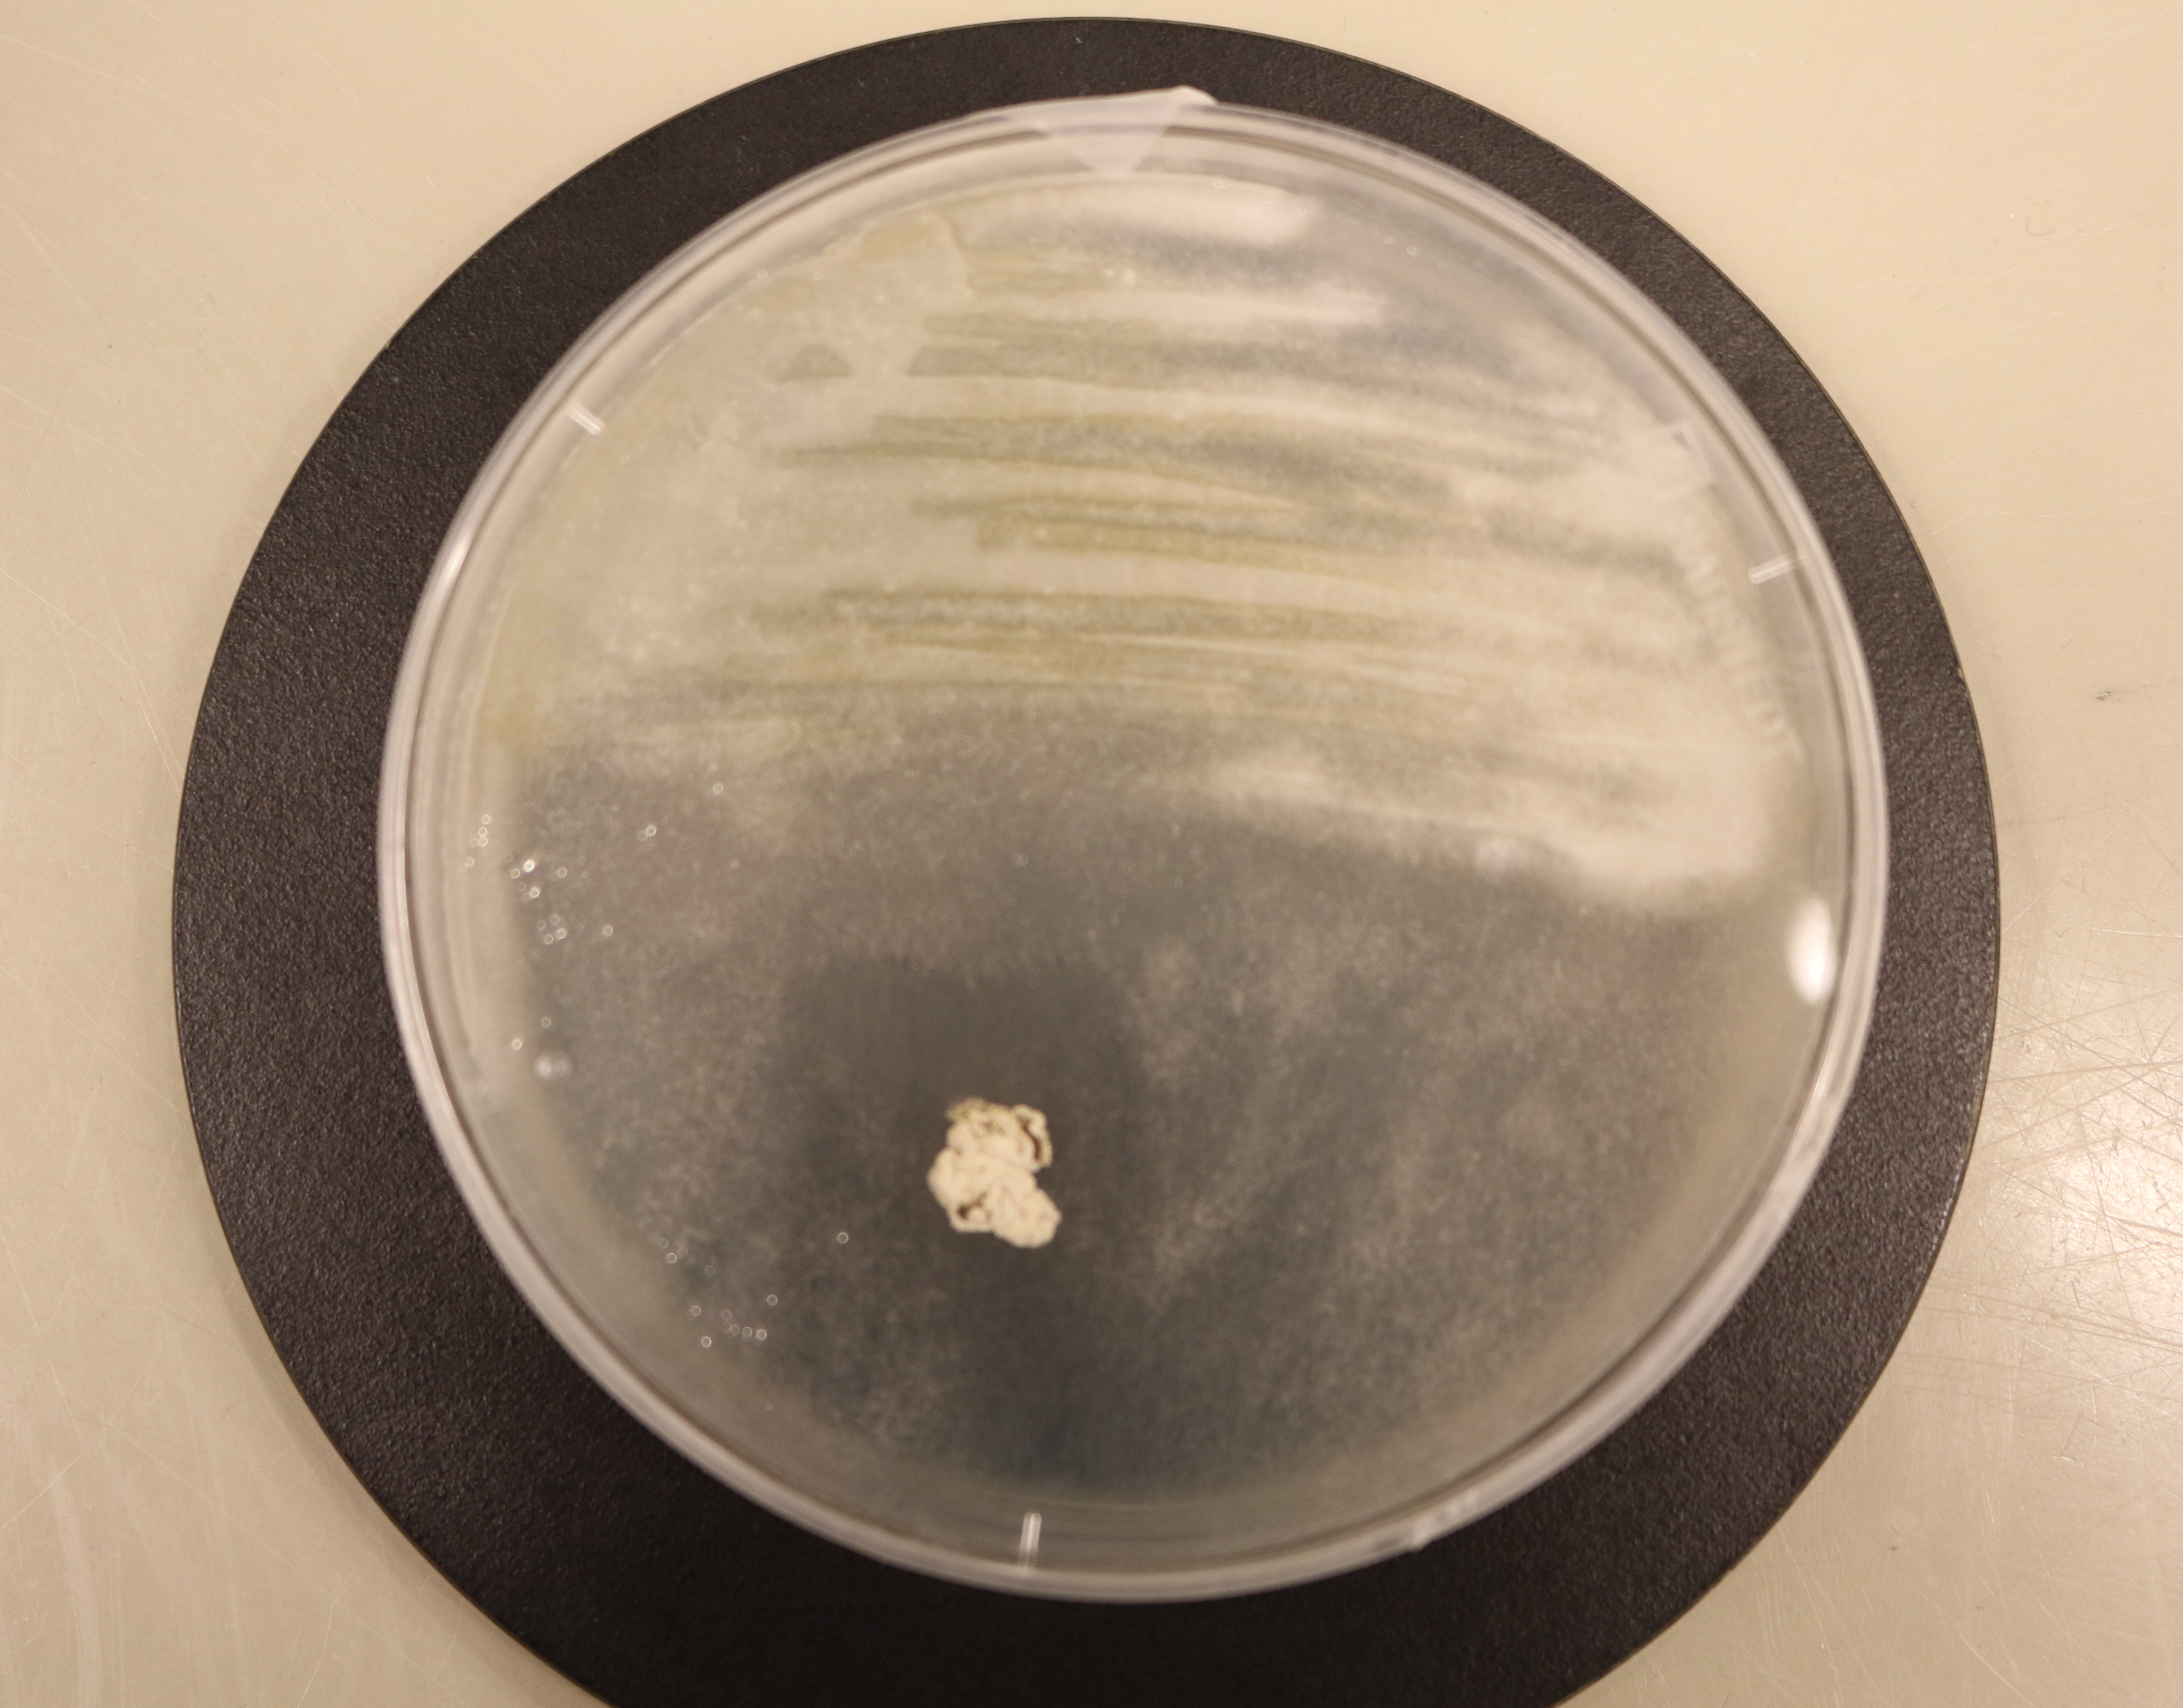

eDNA for terrestrial biodiversity monitoring

Drivers of host-gut microbiome associations

Avian malaria host-pathogen symbiosis

Microbial community assemblies in caves
Uropygial gland microbiomes of birds

Ectosymbionts of birds

Termites and other research